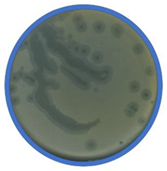
Applmicrobiol 01 00021 i003

Abstract
Background: the aim of this study was to improve the overall microbiological quality of five different sprouts (alfalfa, kale, lentil, sunflower, radish) using newly isolated bacteriophages. Method: in this study we had isolated from sewage 18 bacteriophages targeting bacteria dominant in sprouts. Five selected bacteriophage strains were photographed using a transmission electron microscope (TEM), and we analyzed the rate of attachment, resistance to chloroform, the burst size, and the latency period. Two methods of application of the phage cocktail were investigated: spraying, and an absorption pad. Results: the spraying method was significantly more efficient, and the maximum reduction effect after 48 h of incubation was 1.5 log CFU/g. Using pads soaked with phage lysate reduced the total number of bacteria to only about 0.27–0.79 log CFU/g. Conclusion: the reduction of bacteria levels in sprouts depended on the method of phage application. The blind strategy for searching phage targeting bacteria dominant in sprouts can be useful and economically beneficial as a starting point for further investigation in phage cocktail application for improving the overall microbiological quality of food. The main result of our research is to improve the overall quality of kale and radish sprouts by spraying them with a phage cocktail.
1. Introduction
Sprouts are considered a healthy, ready-to-eat, minimally processed food and have gained popularity in recent years [1,2]. Sprouts are produced from seeds under warm and moist environments, and it is clear that conditions are ideal for the growth of microorganisms [3,4]. Fresh sprouts have been implicated in a number of outbreaks of illness in countries such as Japan, the USA and EU, caused by pathogens [5,6]. The bacterial pathogens most frequently linked to produce-related outbreaks include the bacteria Salmonella spp., E. coli O157:H7 and non-O157 Shiga-toxin E. coli [2]. Liu et al., (2021) pointed out two of the most important problems faced by the sprout industry [7]. First is the improvement of the rapid germination of seeds, and the second is microbial safety. The shelf life of sprouts is short (two to three days), and knowledge of factors controlling spoilage would enable further expansion of this type of product. Food waste has skyrocketed in recent years, and one third of all food produced is lost or wasted. In the EU, around 88 million tons of food waste are generated annually [8] and 103 million tons of food waste was generated in the USA in 2018 (EPA). Sprouts are known to have a poor shelf life, even at low temperatures (4–8 °C) in storage [9], so they are on the list of food products which can be easily wasted. Bacterial spoilage of sprouts is mainly characterized by soft rot, in which maceration of plant tissue by bacterial enzymes results in collapse of the cell wall structure [10].
Many technologies have been studied for improving the nutritional and microbiological quality of sprouts. In addition to physical and chemical methods of preservation, recently attention has been paid to the use of biological methods. One of these concepts is the use of food processing bacterial viruses—bacteriophages.
Bacteriophages (phages) are highly specific and usually can infect only one species or one type of bacteria, and they do not destroy the natural commensal microbiota in the gastrointestinal tract of humans and animals. Phages do not change the sensory properties of food products and are highly resistant to the stress created during food processing [11,12]. The success of phages for use in food depends on the overcoming of a number of barriers, and one of these is the method of phage application. The number of phages used is of great importance. In general, the higher the concentration of phages the more significant the reductions in target bacteria [13]. Phages are applied in three sectors in the food industry: primary production (mainly used to prevent the formation of biofilms on the surface of equipment), bio-sanitization (mainly used in the production facilities), and bio-preservation (used to extend the shelf life of products by combatting pathogenic bacteria that spoil the food). In the case of minimally processed food, a significant problem is the quality reduction of products due to the growth of the accompanying microflora [12]. A lot of studies have been conducted on phage isolation and the effectiveness of phages against pathogenic bacteria such as Salmonella spp., Shigella, E. coli on food or food processing surfaces [13].
In contrast to this, this study aims to analyze the influence of application methods of newly isolated phages cocktails for improving overall microbiological quality (Figure 1).
Figure 1.
General diagram of the steps involved in running the experiment.
2. Material and Methods
2.1. Total Number of Bacteria (TNB) in Sprouts
Commercial packages of alfalfa (Medicago sativa), kale (Brassica oleracea), radish (Raphanus raphanistrum), sunflower (Helianthus annuus) and lentil (Lens culinaris) sprouts were purchased from the supermarkets in Warsaw, Poland, and transported to the laboratory under refrigerated conditions. The net weight of individual products was in the range from 50 g to 150 g. Sprouts packages were opened aseptically by partially removing the thin plastic wrap, and samples of 25 g were weighted and homogenized (Stomacher 400 Circulator; manufacturer: Seward, Worthing, UK) for 1 min at 230 units in 225 mL of buffered peptone water (BPW; BTL, Warsaw, Poland) in stomacher bags. The preparation of samples for microbiological analysis followed the procedure described in ISO 6887-1:2003 [14]. Then, the homogenates were decimally diluted in saline up to 1 × 10−12.
One milliliter of each sample dilution was transferred into the Petri dish and then mixed with 15 mL of plate count agar (PCA; BTL, Warsaw, Poland), in duplicate. The plates were incubated at 4, 20 and 30 ± 1 °C. Bacterial colonies were counted after 48 h (for mesophilic), 96 h (for psychrotrophic) and 144 h (for psychrophilic). The interpretations of the results were carried out in accordance with ISO 4833-1:2013 [15]. The total number of microorganisms was expressed as a decimal logarithm colony forming units per gram (log CFU/g).
2.2. Bacteria Isolation from Sprouts
Mesophilic bacterial strains were obtained by isolating their colonies from PCA agar (during the TNB determination). Single colonies were picked and streaked on nutrient agar (PCA; BTL, Poland), cultured at 30 °C, and repeated many times to ensure a pure bacterial culture. All strains were maintained at −80 °C in Luria Bertani broth (yeast extract 5 g/L, bactotryptone 10 g/L, NaCl 10 g/L, pH 7.2 ± 0.2) supplemented with 20% glycerol.
2.3. The Phages Isolation—A Phage Stock
Samples were taken from a sewage treatment plant in Izabelin “Mokre Łąki”, Poland. After removing coarse impurities, the wastewater samples were centrifuged (10,000 rpm, 10 min, 20 °C) (Eppendorf 5804 R). To obtain a phage stock, the supernatant was filtered using Whatman™ 0.45 µm nylon filters. Finally, phage stock was stored at 4 °C for further investigation.
2.4. The Multiplication of Bacteriophages
The multiplication of selected bacteriophages was performed by mixing 20 mL of phage stock with 20 mL of 2× LB (yeast extract 10 g/L, bactotryptone 20 g/L, NaCl 20 g/L, pH 7.2 ± 0.2) and inoculating with 1 mL of overnight culture isolated from sprout bacterial strains. After 24 h at 28 °C, the mixture was centrifuged (10,000 rpm, 10 min) and filtered (Whatman syringe filters, 0.45 µm aliquot) to obtain an amplified phage lysate [16].
2.5. The Lytic Activity
The lytic activity of the phages against the isolated strains from sprouts was checked by the spot test [16]. In a test tube, LCA (yeast extract 5 g/L, bactotryptone 10 g/L, NaCl 10 g/L, MgSO4 2.5 g/L, CaCl2 2.7 g/L, agar 7 g/L, pH 7.2 ± 0.2) was mixed with 100 μL overnight culture (LB broth) of the isolated bacterial strain and was poured onto plates with a previously solidified layer of LB agar (yeast extract 5 g/L, bactotryptone 10 g/L, NaCl 10 g/L, agar 15 g/L, pH 7.2 ± 0.2). Then, 10 μL of the phage stock was placed on the plate with two agar layers. Plates were incubated at 28 °C for 18 ± 2 h for visualization of plaques. This experiment was independently conducted three times for each phage.
2.6. Phage Titer
The double agar overlay plaque assay method was used for the phage titer determination [16]. The glass tubes containing dissolved LCA were placed in a water bath at 48–52 °C until the temperature equilibrated. Then, 100 μL of 0.025 M CaCl2 and 0.025 M MgSO4 were added to sterile test tubes and incubated with 100 µL of overnight bacterial culture. Then, 100 μL of 10× and 100× diluted phage lysate were transferred to test tubes. After 10 min, the tubes were supplemented with soft LB agar (48–52 °C) to the total volume of 5 mL, mixed, and then poured onto first agar layer and incubated at 30 °C. The results were read after 24 h. A unit was plaque forming unit per mL [PFU/mL]. Then, phage plaques were cut with a scalpel and purified in SM buffer according to the method proposed by Mirzaei and Nilsson [17].
2.7. The Resistance to Chloroform
One milliliter of phage lysate of known phage titer was placed in an Eppendorf tube and 40 μL of chloroform was added. The vortexed mixture was detained for 24 h at 4 °C. Then the phage titers were examined.
2.8. Rate of Attachment of Phage to Cells
The initial procedure for determining the rate of attachment included the determination of growth curves of selected bacterial isolates. For this purpose, one bacterial isolate from one product was selected. The bacterial growth curves were prepared in LB liquid medium, as well as the control curve of the number of cells and corresponding optical density. The OD measurements were made every 30 min at a wavelength of 650 nm using the Rayleigh UV-1800 spectrophotometer. The conical flasks containing 0.95 mL of LB medium were inoculated with 9 mL of bacterial culture (OD650 = 0.2) or 9 mL of sterile LB medium (as control). The flasks were transferred to a water bath (37 °C) and left for 5 min. Then, 1 mL of phage lysate (fixed titer of 1 × 105 PFU/mL) were added. In every minute, 50 μL of sample was taken to a previously ice cooled tube containing 0.95 mL of LB medium and 40 μL of chloroform, intensely stirred, and the phage titer was determined without additional dilutions. The rate of attachment was calculated according to the formula:
where, k—adsorption coefficient (mL/min), B—concentration of bacterial cells calculated on the basis of the OD650 of the culture in the flask with the sample, t—time needed to obtain 50–80% adsorption of bacteriophages to host cells, P0—number of plaques calculated from the mean titer of the control, P—number of plaques at time t.
2.9. Single-Step Growth Curve
The procedure used to calculate the burst size and examine the latency time is called one-step growth. It is used to analyze phage development processes and it plays an important role in the industrial application of bacteriophages. The burst size informs about the amount of active viral particles produced from one infected cell (from one phage); therefore, it does not have its own unit. The value of the latency time is given in minutes. This time is counted from the moment when most of the phages are adsorbed (80%) until the first virions appear.
Single step growth curves were constructed to determine the phage burst sizes and burst times (latency period), according to Park et al. [18], with modifications. Isolated bacteria strains were grown for 24 h at 37 °C in LB broth supplemented with CaCl2 and MgSO4. Then, two mL of culture was added to 9 mL of fresh LB broth and incubated at 37 °C until an optical density at 650 nm (OD650) of 0.5 (stationary phase) was attained. Next, 100 µL of phage lysate titer 1 × 106 PFU/mL was added and allowed to adsorb for 5 min. To remove excess phage particles, the co-culture was centrifuged (4000× g) at 4 °C. The pellets were suspended in 10 mL of fresh LB and incubated at room temperature with gentle agitation. Subsequently, 50 μL aliquots were collected every 5 min for a total duration of 60 min, immediately serially diluted in saline, and spotted in duplicate on a host agar lawn of bacterial isolates grown for titer determination. Plates were incubated at 37 °C for 18 ± 2 h for visualization of plaques. This experiment was independently conducted three times for each phage. Two formulas have been used to approximate the principle:
where: B—burst size, AB—burst average [PFU/mL], Ap—plateau average [PFU/mL], tl—latency period [min], tp—time of appearance of the first progeny viral particles [min], tA—adsorption time of the majority of phages (80%) to the host cells [min].
2.10. Transmission Electron. Microscopy
High titer phage lysates (>109 PFU/mL) were chosen for transmission electron microscopy (TEM) and prepared for imaging, as described previously [19,20]. The procedure of preparing the preparations for the transmission electron microscope began with the initial exposure of the matrix. The matrix was carbon sputtered copper-tungsten grids (Agar Scientific Cat. No. AGS162-6H), which were placed under a laminar chamber and irradiated with UV light. The phage lysate was centrifuged for 30 min at 14,000 rpm (Eppendorf minispin plus). After centrifugation, the supernatant was discarded and the pellet was washed with ammonium acetate (2%). The washing and precipitation procedure was repeated 3 times. The final volume of the phage preparation depended on the phage titer. Next, 2 µL of the purified lysate was placed on the reticules. The lysate mesh was allowed to dry. Then, it was stained with a 2% solution of phosphotungstic acid (time 30 s 2 μL vol). The excess dye was filtered off with a pipette and blotted dry with sterile filter paper. The photos were taken using a transmission electron microscope (Jeol JEM-1220, SIS Morada camera).
2.11. Application of the Phage Cocktail to the Analyzed Products
To prepare the phage cocktail, 10 mL of 18 phage lysates filtered through syringe filters (0.45 µm) were mixed in a sterile Schott bottle. By diluting 2 times with sterile saline, the obtained titer of the phage cocktail was 1.05 × 108 PFU/mL. The cocktail application was carried out using two methods. The first was the use of absorbent pads made of cellulose. The pads were soaked in 20 mL of the phage lysate cocktail. An aliquot of 30 g of selected sprouts were placed on the pad in polystyrene trays and packed in a reduced pressure atmosphere (350 mbar) (MULTIVAC C200). The second method was to spray 30 g of sprouts with the phage cocktail using an atomizer. The amount of cocktail used to spray one sample of sprouts was 5 mL. Sprayed sprouts were placed in polystyrene trays and packed in a reduced (350 mbar) pressure atmosphere. The sprouts were incubated at 20 °C. TPC were made in the following time: 0 h, 6 h, 24 h and 48 h, from the moment of packing. The triple control was determined: the control samples were sprouts products (c), 30 g sprouts sprayed with 5 mL of sterile saline (a), and 30 g sprouts with the 20 mL of sterile saline on an adsorbent pad (b).
2.12. Statistical Analyses
In the analysis of microbiological quality of sprouts and the practical application of the phage cocktail, a two-way analysis of variance with a confidence interval of 0.95 was performed. Statistical tests and calculations were performed using the Statistica 13.1 program.
3. Results
3.1. Microbiological Quality of Sprouts
Radish and sunflower sprouts were characterized by the lowest total number of bacteria in terms of all tested temperatures. The microbial quality of the sprouts is presented in Table 1. Alfalfa sprouts yielded the highest mesophilic (8.14 ± 0.39 log CFU/g) and psychrotrophic plate count (8.18 ± 0.12 log CFU/g). Almost all products were characterized by a lower number of bacteria that provided colonies at 4 °C, and their number ranged from 6.11 ± 0.22 log CFU/g for radish to 7.42 ± 0.13 log CFU/g for lentil sprouts. No significant differences were documented in the mean of psychrophilic, psychrotrophic and mesophilic bacteria numbers of lentil sprouts.
Table 1.
Microbiological quality of sprouts—total number of bacteria (TNB) determined at three different temperatures of incubation.
Despite the high counts, it is important to underline that products did not show any visible signs of spoilage. The similar number of mesophilic aerobic microflora and psychrotrophic microflora means that most of the microorganisms were able to grow at storage temperatures. Storage at refrigeration temperatures is generally selected in favor of the growth of psychrotrophic microorganisms, including the pectinolytic pseudomonads [21]. Nevertheless, mesophilic microorganisms may continue to grow at low temperatures, albeit at reduced growth rates [22].
3.2. Bacteriophages Characteristics
Phage isolation and characterization were the first two steps to select phages for targeting bacteria spoiling sprouts. Finally, 18 bacteriophages, which could infect bacteria from different sprouts, have been isolated from wastewater. For further investigation, only five of the bacteriophages were selected. The phage selection criterion was the origin of the host bacterial strains isolated from different types of sprouts. The multi-stage process ended with examining the effectiveness of two methods of application of phage mix (Figure 1. Graphical abstract). The phage cocktail was sprayed with the sprouts, and in the second method an absorption pad was soaked with the phage cocktail.
Table 2 shows morphological characteristic of phages. All five bacteriophages have been identified as belong to order Caudovirales (tailed, dsDNA). The structure of Caudovirales in general includes a capsid, protein adaptor, collar, tail, baseplate and spikes. In this family, three tail morphologies are well distinguished, including short (Podoviridae), long non-contractile (Siphoviridae), and long contractile (Myoviridae) [23,24]. Phages bAs, bKs, bSs belong to Siphoviridae, and bLs, bRs to Myoviridae.
Table 2.
Morphology of bacteriophages targeting bacteria strains isolated from different sprouts.
TEM photos of isolated bacteriophages linked with their plaque pictures are provided (Table 2). They differ in size and halo. The central part of the plaque zone is related to the size of the phage and its ability to diffuse in soft agar. The halo zone was very visible for the bAs phage, where the stream has been created due to cell lysis and related diffusion of lysins. Halo zones are characteristic for phages targeting bacteria strains isolated from sunflower (bSs), kale (bKs) and lentil sprouts (bLs). Halo zones were not present around the plaques of bRs phages.
Determination of sensitivity of phages to chloroform is useful for rate of attachment determination and for separating phages from bacteria [25]. In this study, the antiphage effect of chloroform (Table 3) was salient for bAs phage targeting bacteria strains isolated from alfalfa sprouts (2.91 log PFU/mL reduction). Besides this, chloroform showed no differences in the reduction of four bacteriophage (bKs, bLs, bSs and bRs) titers after 24 h of exposure. The cause of reducing phage bAs activity could be damage by a structural protein of a virion.
Table 3.
The properties of the isolated bacteriophages targeting bacteria strains isolated from different sprouts.
The rates of attachment of analyzed bacteriophages (Table 3) belonging to Siphoviridae families were very high and the k values were 4.86 × 10−9 and 3.48 × 10−9 for bAs and bSs, respectively. The other bacteriophages have been characterized by the average rate of attachment and the smallest value: 7.53 × 10−10 for the bLs phage was observed. According to De Paepe and Taddei (2006), the coefficient of origin 10−10 indicates bacteriophages deposited belonging to Siphoviridae and Myoviridae families [26]. This confirms the results of identification of isolated phages.
The adsorption time of the bAs phage on the surface of bacterial cells isolated from alfalfa was 4 min, and the latency time was 21 min. The burst size of this phage was 135, and it was the highest value. Nearly 80% of bSs virions adsorbed to bacterial receptors within 4 min, and the increasing number of PFU/mL had been seen after the 30th minute; therefore, the estimated latent period was 26 min. The burst size was 79. Bacteriophage targeting bacteria from lentil sprouts stand out from other phages, as they have the longest time (10 min) of adsorption. The differences between the burst size of phages results in the size of phage particles. Weinbauer and Peduzzi (1994) noticed that by increasing the size of capsid, the number of released virions decreased. In this study, the capsid of phage bAs was rather small (<60 nm). The burst size also depends on physiological conditions and host cell morphology, and generally it is higher for phages targeting bacilli than cocci [27].
3.3. Effect of Phage Cocktail Method of Application
The success of phages for use in food depends on the overcoming of a number of barriers, and one of these is the method of phage application. The number of phages used is of great importance. In general, the higher the concentration of phages the more significant the reductions in target bacteria [13].
A phage cocktail in a traditional lysate form was added by spraying method (A) and soaked up with an adsorbent pad made of cellulose (B). After 6 h of incubation, packed sprouts with the phage cocktail which had been added to the adsorption pad and (B) the total number of bacteria was at the same average level. Surprisingly, the spraying method (A) resulted in an increase of number of bacteria in all products during first six hours (data not shown). This phenomenon can be explained through the fact that moisture and water activity has been grown by cocktail application, and water had better contact with the surface of sprouts compared to the adsorbent pad.
After the first day of incubation with the pad soaked with phage lysate, the reduction of the total number of bacteria was observed in all sprouts, except alfalfa (Table 4). The highest reduction level was characterized by the bacteria from sunflower (0.79 log CFU/g) and lentil sprouts (0.29 log CFU/g). The reduction of bacteria number was average for the rest of the products (radish and kale sprouts). Over the next 24 h, the number of bacteria were reduced by about 0.18 log CFU/g for radish, 0.27 log CFU/g for sunflower, 0.30 log CFU/g for lentil, 0.40 log CFU/g for kale and 0.51 log CFU/g for alfalfa sprouts.
Table 4.
The reduction level of the total number of bacteria after phage cocktail application and incubation.
The use of the spraying method allowed us to reduce the number of bacteria in tested products. Almost all sprouts contained lower bacteria cells after 24 h, compared to the control and to the pad method, with the exception of lentil sprouts (0.14 log CFU/g). Along with the time of incubation, the reduction level increased. Therefore, the average reduction level after two days of incubation was 0.39 log CFU/g for lentil sprouts, and there was no significant differences between two methods. Further, a not very vast reduction was observed for alfalfa sprouts. The differences in bacteria numbers in sunflower sprouts with and without sprayed lysate was 0.59 log CFU/g. Satisfactory reduction levels were achieved for kale sprouts (1.1 log CFU/g) and for radish sprouts, with values of 1.5 log CFU/g.
4. Discussion
4.1. Microbiological Quality of Sprouts
Most of the analyzed sprout samples can be classified as products with high microbiological contamination. Surveys performed in different countries revealed that total plate count (TPC), also known as aerobic plate counts (APC), total aerobic counts (TAC), or total count of aerobic mesophilic bacteria (TAMB), may range between 5 and 11 log CFU/g in various sprouts [4,6,28,29,30,31,32,33,34,35]. The total number of microorganisms in specific sprouts described by other authors were 1 × 109 CFU/g to 1 × 1010 CFU /g for alfalfa and radish sprouts [29,30]. The high bacterial contamination of products exceeding 109 CFU/g was also confirmed for lentil and sunflower sprouts [36]. The results described in this paper generally agree with those obtained in previous studies.
In these food products, the number of bacteria is very high because of the intrinsic microflora of seeds and the favorable environment during sprout growth [37]: abundant moisture, suitable temperature and nutrients. The sprouts are very active products by which a large amount of moisture is collected on an internal layer of packaging. Additionally, the pH of sprouts oscillates around 6, which favors the proliferation of many microorganisms [38]. However, elevated levels of microbial contamination in sprouts could also be due to unsanitary sprouting conditions and poor hygienic practices of producers and retailers [28]. The microorganism limit in minimally processed food specified by some UE countries is 5 × 107 CFU/g. This implies that the examined products did not meet the standards. In addition, the packages of all analyzed sprouts in this experiment provided no information about the need for product washing before consumption. Sprouts are consumed in relatively small quantities, as condiments or garnishes, which could tend to reduce the risk of eating an infective dose. Consumers can decrease potential risks by washing sprouts before use.
The number of bacterial mesophilic aerobic microflora present in analyzed sprout products was very similar to that of psychotropic microflora, and therefore most of the microorganisms were able to grow at storage temperatures.
Microbiome analyses contribute to an in-depth understanding of the microbial ecology of sprouts, leading to improvement of food safety and quality. Earlier studies of different authors provided a comparative examination of the microbial profiles of sprouts. The dominant microflora of sprouts produced in Poland was bacteria belong to Enterobacteriaceae and representatives of the genera Pseudomonas, Vibiro and Aeromonas [36]. Proteobacteria was the most abundant phylum (98.5–97.3%) associated with fresh sprouts of alfalfa from Israel at the time of purchase, in alfalfa. Firmicutes represented relative abundance of 1.3% and 2.1% in alfalfa, and was the second most abundant phylum. The other 10 phyla, namely Verrucomicrobia, Cyanobacteria, Bacteroidetes, Actinobacteria, Chlamydiae, Deferribacteres, Marinimicrobia, Acidobacteria, Planctomycetes, and Dependentiae, were represented in relative abundance of less than 0.1%. The most abundant in alfalfa are the Proteobacterial species belonged to the genus Pseudomonas (48.8–29.5%), Janthinobacterium (9%) and Duganella (5%) [4]. Similar findings were reported by Jiang et al. 2021), where Proteobacteria was the dominant phylum in South Korean alfalfa sprouts (79.0%) and radish sprouts (61.9%). Enterobacteriaceae was the dominant family in alfalfa sprouts (33.9%) while Moraxellaceae (11.9%) were prevalent on radish sprouts [39]. The majority of the dominant genera were common in the environment, such as soil or water.
Although no pathogens in commercially available products were observed [4,32,35], raw sprouts have been implicated in many outbreaks of foodborne diseases [40]. A number of studies have reported low incidences of Salmonella and Listeria monocytogenes [6,28,34,41]. While the presence of Salmonella is a food safety criterion, that of E. coli is a hygienic criterion. The presence of the pathogenic E. coli O157:H7 [6,41,42] was determined in different sprouts. In alfalfa and sunflower sprouts, Cronobacter sakazakii isolates sensitive to 7 different antibiotics were identified [43].
Bacterial spoilage of sprouts is characterized by softening as a result of enzymatic activity. The gram-negative E. carotovora and pectinolytic strains of Pseudomonas fluorescens are the most important bacteria causing soft rot of sprouts [10]. Appropriate treatment development can be an effective strategy to promote greater marketability, by extending shelf life and ensuring safety.
4.2. Characteristic of Bacteriophages
Phages can be found in all environments that are colonized by viable bacteria: sewage, soil, water, human and animal secretions and excrements [44,45]. Moreover, bacteriophages can settle in extreme environments because of their resistance to unfavorable physical and chemical factors, such as low and high temperatures, pH, salinity, and ions [46]. In this study, we had isolated 18 phages targeting bacteria dominant in sprouts, which confirmed that sewage can be a source of bacterial viruses.
Phages bAs, bKs, bSs belong to Siphoviridae, and bLs, bRs to Myoviridae. The capsids of these two phage families are a proteinaceous shell which protects the genetic material and are connected to the tail by a protein adaptor playing an important role in DNA packaging and ejection [24,47]. Myoviridae phages contain an additional ring-shaped structure which is formed around the tail tube to form a contractile sheath The tail is a continuous channel (central tube) located between the protein adaptor and the base plate. This structure is implicated in the DNA ejection of the phage toward the host cell cytoplasm [24]. Siphoviridae have the simplest structure and possess tails, and their genome is smaller. Phages from the Myoviridae (e.g., T2) and Siphoviridae (e.g., T1, T5) families may be extremely resistant to a dry environment, and may also survive large temperature fluctuations [48]. The members of the Siphoviridae family are generally the most resistant to adverse conditions [49], as T5 phage proved to be very resistant to long-term storage [50]. Most complex phages are resistant to chloroform, e.g., T4, because in the virion the structure does not contain lipids [51]. Moreover, some bacteriophages, although they do not contain lipids, may be sensitive to chloroform. The trait of resistance facilitates the commercial use of bacteriophages. Phage i3 targeting Mycobacterium is an example that there is a possible reduction in the effectiveness of bacteriophage infection after exposure to chloroform. Determination of the sensitivity of phages to chloroform is useful for rate of attachment determination and for separating phages from bacteria [25]. The isolated bacteriophages have been characterized by the average rate of attachment and the smallest value, 7.53 × 10−10, was for the bLs phage.
Isolated phages differ in size and morphology of plaques. The typical circular plaque morphology is the result of cycles of infection of the host cells by the numerous viruses disseminating in all directions from the original focus of infection. However, the effect of phage morphology on plaque size cannot be tested simply by comparing between phages. Gallet et al. (2011) showed that the adsorption rate negatively impacts plaque size, plaque productivity, and phage concentration in plaques. A smaller plaque size is connected with a larger virion size. On the other hand, the plaque size is at its maximum when the lysis time is intermediate in length [52].
Considering the use of bacteriophages in food technology, virulent phages should be searched for as their development will lead to the rapid damage of bacterial cells [53,54]. Virulent bacteriophages usually exhibit the lytic cycle, which entails an immediate transition of bacteria into phage metabolism. In a lysogenic cycle, the genome of bacteriophages becomes integrated with a bacterial chromosome and enters into the latent state.
4.3. Effect of Phage Cocktail Application Method
Application of the phage cocktail was predominantly effective against bacteria detected in radish sprouts. Since different groups of phages recognize different receptors on host cells, a phage cocktail mix therefore could potentially delay the development of bacterial resistance, or even prevent it. The reduction of bacteria levels in sprouts depended on the method of phage application. The spraying method was significantly more efficient, and the maximum reduction effect was 1.5 log CFU/g. Using pads soaked with phage lysate reduced the total number of bacteria by only about 0.27–0.51 log CFU/g after 48 h of incubation.
Several investigators indicated that alfalfa seeds are generally the most difficult type of seed to sanitize effectively. Indeed, our results confirmed that the phage cocktail was not as efficient as against kale and radish sprouts. Some authors have speculated that, for example, Salmonella may be trapped in cracks and crevices on the seeds [55]. In our opinion, the kale and radish sprouts have been dominated with a larger number of bacteria strain cells that were targets of phages from the cocktail. Active viruses have reduced their number, and because they originally had dominated in the environment, a statistically significant improvement in microbiological quality has been visible.
The concept of using phage cocktails to reduce the total number of bacteria has not been published so far. Therefore, it is difficult to relate our data to the results of other authors. However, commercially available phage cocktails targeting food pathogens show similar reduction effects in meat products. Applied to the surface of chicken breast fillets, SalmoFreshTM reduces the Salmonella number by about 0.6–1.1 log CFU/g [56]. ShigaShieldTM sprayed on smoked salmon reduces the numbers of Shigella sonnei by about 0.16 log CFU/g to 1.09 log CFU/g (according to MOI) [57]. The multiplicity of infection (MOI) is the ratio of the number of infecting virus molecules to the number of bacterial cells. The cocktail of EcoM-HG2, EcoM-HG7, and EcoM-HG8 phages aimed at E. coli in alfalfa sprouts also significantly reduced number of bacteria when it was applied to surface [58]. Our results confirmed that the spraying method, when applied to surfaces, provided different levels of effectiveness in reduction of the total number of bacteria.
On the other hand, using larger spray volumes might physically reduce the number of bacteria on the sprouts. Washing seeds with water alone decreases levels of B. cereus, E. coli or Salmonella by 1 log [59]. A ninety percent reduction of the detected microbial contaminants was achieved by the AEW washing for a brief period of 20 s [60]. However, the total number of bacteria determined after treatment with the phage cocktail was lower than in the control samples “washed” with the same volume of saline (control a). Although dipping and spraying are common methods for phage application, they can have negative effects [37]. Spraying can release phage particles into the environment, and spraying equipment may not be available in the processing environment [13]. Other techniques of sprout preservation have been enhanced. For example, the combination of blanching (60 °C; 7 min) or thermosonication (60 °C; 7 min), cold ascorbate dip (4 °C; 0.5%; 5 min), air drying (30 min), packaging (either in polystyrene tray covered with a cling film or LDPE packets) and irradiation (2.5 kGy) are efficient in sprout preservation [9]. In contrast to these expensive and power consuming techniques, the phage biocontrol seems to be the most environmentally friendly antimicrobial intervention available nowadays.
The efficacy of phage treatment is concentration-dependent, and using more phage is likely to yield a better reduction of the targeted bacteria’s cell numbers [57,61]. Bacteriophages must come into contact with susceptible bacterial cells to lyse them. When high titers are applied, phages are capable of absorbing the bacterial cells, causing lysis to the cytoplasmic membrane without replication [62]; therefore, using high concentrations of phages generally achieved high reduction rates of pathogens [63,64]. However, if phages are to be successfully deployed in food, multiple barriers must be overcome. According to Lewis and Hill (2020), these also include the physico-chemical properties of the food or target method, the time of application, and which phages are chosen. The phage instability in acidic environments is well documented.
Other factors should also be considered, such as the presence of molecules with antiphage activity (e.g., organic acids, tannins). Other substances have been identified as responsible for antiviral activity, including high salt and sucrose concentrations, fatty acids, alcohols, retinoids, and cationic compounds [65].
5. Conclusions
Our data suggest phage preparations with potent lytic activity against dominating bacteria in sprouts may offer an effective approach for reducing the levels of bacteria in various foods that may become contaminated. This blind strategy for searching for phages targeting bacteria can be useful and economically beneficial as a starting point for further investigation in phage cocktail applications on food. This study established that a spraying method can be commonly applied to surfaces to provide different levels of effectiveness in the reduction of the total number of bacteria.
According to the fact that all phage genomes should be well suited for biocontrol applications, each phage genome should be fully sequenced and annotated to determine whether there were any virulent and/or toxic genes present; this is important for safety implications. This problem merits further investigation.
The main result of our research is to improve the overall quality of kale and radish sprouts by spraying them with a phage cocktail.
Author Contributions
This work was carried out in collaboration with all authors. Conceptualization, I.G., A.W.Ż. and S.B.; formal analysis, M.W. and A.W.Ż.; methodology, I.G., M.W. and A.W.Ż.; supervision, I.G. and S.B.; validation, I.G.; visualization, A.W.Ż., I.G. and M.W.; writing—original draft, I.G.; writing—review & editing, I.G. and M.W. All authors have read and agreed to the published version of the manuscript.
Funding
This research received no external funding and was financially supported by Institute of Food Technology, Warsaw University of Life Sciences-SGGW, Nowoursynowska 159c Str., Warsaw, Poland.
Institutional Review Board Statement
Not applicable.
Informed Consent Statement
Not applicable.
Data Availability Statement
Not applicable.
Conflicts of Interest
The authors declare no conflict of interest.
References
- Vermeulen, A.; Devlieghere, F.; Ragaert, P. Optimal packaging design and innovative packaging technologies for minimally processed fresh produce. In Quantitative Methods for Food Safety and Quality in the Vegetable Industry; Pérez-Rodríguez, F., Skandamis, P., Valdramidis, V., Eds.; Springer: Cham, Switzerland, 2018; pp. 193–212. [Google Scholar]
- Lewis, R.; Bolocan, A.S.; Draper, L.A.; Ross, R.P.; Hill, C. The effect of a commercially available bacteriophage and bacteriocin on Listeria monocytogenes in Coleslaw. Viruses 2019, 11, 977. [Google Scholar] [CrossRef] [Green Version]
- Barak, J.; Whitehand, L.; Charkowski, A. Differences in Attachment of Salmonella enterica Serovars and Escherichia coli O157:H7 to Alfalfa Sprouts. Appl. Environ. Microb. 2002, 68, 4758–4763. [Google Scholar] [CrossRef] [Green Version]
- Keshri, J.; Krouptiski, Y.; Abu-Fani, L.; Achmon, Y.; Bauer, T.S.; Zarka, O.; Maler, I.; Pinto, R.; Saldinger, S.S. Dynamics of bacterial communities in alfalfa and mung bean sprouts during refrigerated conditions. Food Microbiol. 2019, 84, 103261. [Google Scholar] [CrossRef] [PubMed]
- Olsen, S.J.; MacKinon, L.C.; Goulding, J.S.; Slutsker, L. Surveillance for foodborne disease outbreaks–United States, 1993–1997. Morb. Mortal. Wkly. Rep. 2000, 49, 1–51. [Google Scholar]
- Abadias, M.; Usall, J.; Anguera, M.; Solsona, C.; Viñas, I. Microbiological quality of fresh, minimally-processed fruit and vegetables, and sprouts from retail establishments. Int. J. Food Microb. 2008, 123, 121–129. [Google Scholar] [CrossRef]
- Liu, H.K.; Li, Z.H.; Zhang, X.W.; Liu, Y.P.; Hu, J.P.; Yang, C.W.; Zhao, X.Y. The effects of ultrasound on the growth, nutritional quality and microbiological quality of sprouts. Trends Food Sci. Technol. 2021, 111, 292–300. [Google Scholar] [CrossRef]
- FUSION. Reducing Food Waste through Social Innovation. Estimates of European Food Waste Levels; FUSION: Stockholm, Sweden, 2016. [Google Scholar]
- Kumara, S.; Gautam, S. A combination process to ensure microbiological safety, extend storage life and reduce anti-nutritional factors in legume sprouts. Food Biosci. 2019, 27, 18–29. [Google Scholar] [CrossRef]
- Lund, B.M. Bacterial spoilage. In Post Harvest Pathology of Fruits and Vegetables; Dennis, C., Ed.; Academic Press: London, UK, 1983; pp. 219–257. [Google Scholar]
- Kazi, M.; Annapure, U.S. Bacteriophage biocontrol of foodborne pathogens. J. Food Sci. Technol. 2016, 53, 1355–1362. [Google Scholar] [CrossRef] [PubMed] [Green Version]
- Wójcicki, M.; Błażejak, S.; Gientka, I.; Brzezicka, K. The concept of using bacteriophages to improve the microbiological quality of minimally-processed foods. Acta Sci. Pol. Technol. Aliment. 2019, 18, 373–383. [Google Scholar] [CrossRef]
- Lewis, R.; Hill, C. Overcoming barriers to phage application in food and feed. Curr. Opin. Biotechnol. 2020, 61, 38–44. [Google Scholar] [CrossRef]
- Microbiology of Food and Animal Feeding Stuffs. Preparation of Test Samples, Initial Suspension and Decimal Dilutions for Microbiological Examination–Part 1: General Rules for the Preparation of the Initial Suspension and Decimal Dilutions. International Standard 2003, ISO 6887-1. Available online: https://www.iso.org/standard/63335.html (accessed on 10 May 2021).
- Microbiology of the Food Chain. Horizontal Method for the Enumeration of Microorganisms—Part 1: Colony Count at 30 °C by the Pour Plate Technique. ISO 2013, 4833–1. Available online: https://www.iso.org/standard/53728.html (accessed on 22 April 2021).
- Kropinski, M.A.; Mazzocco, A.; Waddell, T.E.; Linghor, E.; Johnson, R.P. Enumeration of Bacteriophages by Double Agar Overlay Plaque Assay. In Bacteriophages: Methods and Protocols, Volume 1: Isolation, Characterization, and Interactions; Clokie, M.R.J., Kropinski, A., Eds.; Humana Press: Totowa, NJ, USA, 2009; Volume 501. [Google Scholar]
- Mirzaei, M.K.; Nilsson, A.S. Isolation of phages for phage therapy: A comparison of spot tests and efficiency of plating analyses for determination of host range and efficacy. PLoS ONE 2015, 10, e0118557. [Google Scholar] [CrossRef] [Green Version]
- Park, M.; Lee, J.H.; Shin, H.; Kim, M.; Choi, J.; Kang, D.H.; Heu, S.; Ryu, S. Characterization and comparative genomic analysis of a novel bacteriophage, SFP10, simultaneously inhibiting both Salmonella enterica and Escherichia coli O157:H7. Appl. Environ. Microbiol. 2012, 78, 58–69. [Google Scholar] [CrossRef] [Green Version]
- Deveau, J.; Labrie, S.J.; Chopin, M.C.; Moineau, S. Biodiversity and classification of lactococcal phages. Appl. Environ. Microbiol. 2006, 72, 4338–4346. [Google Scholar] [CrossRef] [PubMed] [Green Version]
- Ackermann, H.-W. Basic Phage Electron Microscopy. In Bacteriophages: Methods and Protocols, Volume 1: Isolation, Characterization, and Interactions; Clokie, M.R.J., Kropinski, A., Eds.; Humana Press: Totowa, NJ, USA, 2009; Volume 501. [Google Scholar]
- Nguyen-the, C.; Carlin, F. The microbiology of minimally processed fresh fruits and vegetables. Crit. Rev. Food Sci. Nutr. 1994, 34, 371–401. [Google Scholar] [CrossRef] [PubMed]
- Vescovo, M.; Torriano, S.; Orsi, C.; Macchiarolo, F.; Scolari, G. Application of antimicrobial-producing lactic acid bacteria to control pathogens in ready-to-use vegetables. J. Appl. Bacteriol. 1996, 81, 113–119. [Google Scholar] [CrossRef] [PubMed]
- Ackermann, H.W. 5500 Phages examined in the electron microscope. Arch. Virol. 2007, 152, 227–243. [Google Scholar] [CrossRef] [PubMed]
- Tavares, P. The Bacteriophage Head-to-Tail Interface. In Virus Protein and Nucleoprotein Complexes. Subcellular Biochemistry; Harris, J., Bhella, D., Eds.; Springer: Singapore, 2018; Volume 88. [Google Scholar] [CrossRef]
- King, M.Q.A.; Adams, M.J.; Carstens, E.B.; Lefkowitz, J.E. Virus Taxonomy Classification and Nomenclature of Viruses Ninth Report of the International Committee on Taxonomy of Viruses; Elsevier: Oxford, UK, 2012. [Google Scholar]
- De Paepe, M.; Taddei, F. Viruses’ Life History: Towards a mechanistic basis of a trade-off between survival and reproduction among phages. PLoS Biol. 2006, 4, e0040193. [Google Scholar] [CrossRef] [Green Version]
- Weinbauer, M.G.; Peduzzi, P. Frequency, size and distribution of bacteriophages in different marine bacterial morphotypes. Marine Ecol. Prog. 1994, 108, 11–20. [Google Scholar] [CrossRef]
- Gabriel, A.A.; Berja, M.C.; Estrada, A.P.; Lopez, M.A.; Nery, J.B.; Villaflor, E.B. Microbiology of retail mung bean sprouts vended in public markets of National Capital Region, Philippines. Food Control 2007, 18, 1307–1313. [Google Scholar] [CrossRef]
- Michalczyk, M.; Kowalińska, J. Zanieczyszczenie mikrobiologiczne kiełkowalnych nasion dostępnych w handlu. Żywność. Nauka. Technol. Jakość 2009, 3, 32–39. [Google Scholar]
- Lewicki, P.P. Kiełki nasion jako źródło cennych składników odżywczych. Żywność. Nauka. Technol. Jakość 2010, 73, 18–33. [Google Scholar]
- Seo, Y.H.; Jang, J.H.; Moon, K.D. Microbial evaluation of minimally processed vegetables and sprouts produced in Seoul, Korea. Food Sci. Biotechnol. 2010, 19, 1283–1288. [Google Scholar] [CrossRef]
- Althaus, D.; Hofer, E.; Corti, S.; Julmi, A.; Stephan, R. Bacteriological survey of ready-to-eat lettuce, fresh-cut fruit, and sprouts collected from the Swiss market. J. Food Prot. 2012, 75, 1338–1341. [Google Scholar] [CrossRef]
- Kim, S.A.; Kim, O.M.; Rhee, M.S. Changes in microbial contamination levels and prevalence of foodborne pathogens in alfalfa (Medicago sativa) and rapeseed (Brassica napus) during sprout production in manufacturing plants. Lett. Appl. Microbiol. 2013, 56, 30–36. [Google Scholar] [CrossRef]
- D’Sa, E.; Paulin, S.; Anderson, G.; Xavier, R.; Castle, M.; Cook, R.A. Microbiological Survey of Seed Sprouts (and Shoots) Available in New Zealand MPI Technical Report-Paper. 2015. Available online: https://www.mpi.govt.nz/dmsdocument/12939/direct (accessed on 15 April 2021).
- Iacumin, L.; Comi, G. Microbial quality of raw and ready-to-eat mung bean sprouts produced in Italy. Food Microbiol. 2019, 82, 371–377. [Google Scholar] [CrossRef]
- Leszczyńska-Fik, A.; Fik, M. Kiełki roślinne: Jakość mikrobiologiczna skiełkowanych nasion. Przem. Ferm. Owo-Warz. 2003, 47, 29–31. [Google Scholar]
- Buck, J.W.; Walcott, R.R.; Beuchat, L.R. Recent trends in microbiological safety of fruits and vegetables. Online. Plant Health 2003, 4. [Google Scholar] [CrossRef] [Green Version]
- Wójcicki, M.; Żuwalski, A.; Gientka, I.; Błażejak, S. Ocena Jakości Mikrobiologicznej Żywności Minimalnie Przetworzonej Podczas Przechowywania. In Problematyka nauk technicznych i przyrodniczych-Tom 1, XXII Międzynarodowa Konferencja Studenckich Kół Naukowych; Dyjakon, A., Krzyś, A., Eds.; Uniwersytet Przyrodniczy we Wrocławiu: Wroclaw, Poland, 2017. [Google Scholar]
- Jang, M.I.; Kim, S.Y.; Ricka, S.C.; Rhee, M.S.; Kim, S.A. Microbial ecology of alfalfa, radish, and rapeseed sprouts based on culture methods and 16S rRNA microbiome sequencing. Food Res. Int. 2021, 144. [Google Scholar] [CrossRef] [PubMed]
- Fett, W.F. Intervetions to ensure the microbial safety of sprouts. In Microbiology of Fruits and Vegetables; Sapers, G.M., Gorny, J.R., Yousef, A.E., Eds.; Taylor & Francis: Bocaraton, FL, USA, 2006; pp. 187–209. [Google Scholar]
- Seow, J.; Agoston, R.; Phua, L.; Yuk, H.G. Microbiological quality of fresh vegetables and fruits sold in Singapore. Food Control 2012, 25, 39–44. [Google Scholar] [CrossRef]
- Robertson, L.J.; Johannessen, G.S.; Gjerde, B.K.; Loncarevic, S. Microbiological analysis of seed sprouts in Norway. Int. J. Food 2002, 75, 119–126. [Google Scholar] [CrossRef]
- Berthold-Pluta, A.; Garbowska, M.; Stefańska, I.; Pluta, A. Microbiological quality of selected ready-to-eat leaf vegetables, sprouts and non-pasteurized fresh fruit-vegetable juices including the presence of Cronobacter spp. Food Microb. 2017, 65, 221–230. [Google Scholar] [CrossRef]
- Międzybrodzki, R.; Kłak, M.; Jończyk-Matysiak, E.; Bubak, B.; Wójcik, A.; Kaszowska, M.; Weber-Dąbrowska, B.; Łobocka, M.; Górski, A. Means to facilitate the overcoming of gastric juice barier by a therapeutic staphylococcal bacteriophage A5/80. Front. Microbiol. 2017, 8, 467. [Google Scholar] [CrossRef] [Green Version]
- Clokie, M.R.; Millard, A.D.; Letarov, A.V.; Heaphy, S. Phages in nature. Bacteriophage 2011, 1, 31–45. [Google Scholar] [CrossRef] [PubMed] [Green Version]
- Jończyk, E.; Kłak, M.; Międzybrodzki, R.; Górski, A. The influence of external factors on bacteriophages—Review. Folia Microbiol. 2011, 56, 191–200. [Google Scholar] [CrossRef] [Green Version]
- Cuervo, A.; Carrascosa, J.L. Bacteriophages: Structure; John Wiley & Sons, Ltd.: Chichester, UK, 2012; pp. 1–12. [Google Scholar] [CrossRef]
- Prigent, M.; Leroy, M.; Confalonieri, F.; Dutertre, M.; DuBow, M.S. A diversity of bacteriophages forms and genomes can be isolated from the surface sands of Sahara Desert. Extremophiles 2005, 9, 289–296. [Google Scholar] [CrossRef] [PubMed]
- Lasobras, J.; Muniesa, M.; Lucena, F.; Jofre, J. Relationship between the morphology of bacteriophages and their persistence in the environment. Water Sci. Technol. 1997, 35, 129–132. [Google Scholar] [CrossRef]
- Ackermann, H.W.; Tremblay, D.; Moineau, S. Long-term bacteriophage preservation. WFCC Newslett. 2004, 38, 35–40. [Google Scholar]
- Gill, J.J.; Hyman, P. Phage choice, isolation, and preparation for phage therapy. Curr. Pharm. Biotechnol. 2010, 11, 2–14. [Google Scholar] [CrossRef] [PubMed]
- Gallet, R.; Kannoly, S.; Wang, I.N. Effects of bacteriophage traits on plaque formation. BMC Microbiol. 2011, 11, 181. [Google Scholar] [CrossRef] [Green Version]
- EFSA. Evaluation of the safety and efficacy of Listex P100 for reduction of pathogens on different ready-to-eat (RTE) food products. EFSA J. 2016, 14, e04565. [Google Scholar]
- Gutiérrez, D.; Rodríguez-Rubio, L.; Fernández, L.; Martínez, B.; Rodríguez, A.; García, P. Applicability of commercial phage-based products against Listeria monocytogenes for improvement of food safety in Spanish dry-cured ham and food contact surfaces. Food Control. 2017, 73, 1474–1482. [Google Scholar] [CrossRef]
- Beuchat, L.R. Comparison of chemical treatments to kill Salmonella on alfalfa seeds destined for sprout production. Int. J. Food Microbiol. 1997, 34, 329–333. [Google Scholar] [CrossRef]
- Sukumaran, A.T.; Nannapaneni, R.; Kiess, A.; Sharma, C.S. Reduction of Salmonella on chicken meat and chicken skin by combined or sequential application of lytic bacteriophage with chemical antimicrobials. Int. J. Food Microbiol. 2015, 207, 8–15. [Google Scholar] [CrossRef] [PubMed]
- Soffer, N.; Woolston, J.; Li, M.; Das, C.; Sulakvelidze, A. Bacteriophage preparation lytic for Shigella significantly reduces Shigella sonnei contamination in various foods. PLoS ONE 2017, 12, e0175256. [Google Scholar] [CrossRef] [PubMed] [Green Version]
- Ramirez, K.; Cazarez-Montoya, C.; Lopez-Moreno, H.S.; Castro-del Campo, N. Bacteriophage cocktail for biocontrol of Escherichia coli O157:H7: Stability and potential allergenicity study. PLoS ONE 2018, 13, e0195023. [Google Scholar] [CrossRef] [PubMed] [Green Version]
- Potter, A.P.; Ehrenfeld, E.E. Microbial loads of bean sprouts: Coliform, E. coli and Salmonella. In Proceedings of the 98th General Meeting of the American Society for Microbiology, Atlanta, GA, USA, 17–21 May 1998. [Google Scholar]
- Puligundla, P.; Kim, J.W.; Mok, C. Broccoli sprout washing with electrolyzed water: Effects on microbiological and physicochemical characteristics. LWT Food Sci. Technol. 2018, 92, 600–606. [Google Scholar] [CrossRef]
- Worley-Morse, T.O.; Zhang, L.; Gunsch, C.K. The long-term effects of phage concentration on the inhibition of planktonic bacterial cultures. Environ. Sci. Process. Impacts 2013, 16, 81–87. Available online: http://www.ncbi.nlm.nih.gov/pubmed/24301469 (accessed on 20 April 2021). [CrossRef]
- Hooton, S.P.; Atterbury, R.J.; Connerton, I.F. Application of a bacteriophage cocktail to reduce Salmonella Typhimurium U288 contamination on pig skin. Int. J. Food Microbiol. 2011, 151, 157–163. [Google Scholar] [CrossRef]
- Bigwood, T.; Hudson, J.A.; Billington, C. Influence of host and bacteriophage concentrations on the inactivation of food-borne pathogenic bacteria by two phages. FEMS Microbiol. Lett. 2010, 291, 59–64. [Google Scholar] [CrossRef]
- Duc, H.M.; Son, H.M.; Honjoh, K.I.; Miyamoto, T. Isolation and application of bacteriophages to reduce Salmonella contamination in raw chicken meat. LWT 2018, 91, 353–360. [Google Scholar] [CrossRef]
- García-Anaya, M.C.; Sepúlveda, D.R.; Rios-Velasco, C.; Zamudio-Flores, P.B.; Sáenz-Mendoza, A.I.; Acosta-Muñiz, C.H. The role of food compounds and emerging technologies on phage stability. Innov. Food Sci. Emerg. Technol. 2020, 64, 102436. [Google Scholar] [CrossRef]
Publisher’s Note: MDPI stays neutral with regard to jurisdictional claims in published maps and institutional affiliations. |
© 2021 by the authors. Licensee MDPI, Basel, Switzerland. This article is an open access article distributed under the terms and conditions of the Creative Commons Attribution (CC BY) license (https://creativecommons.org/licenses/by/4.0/).